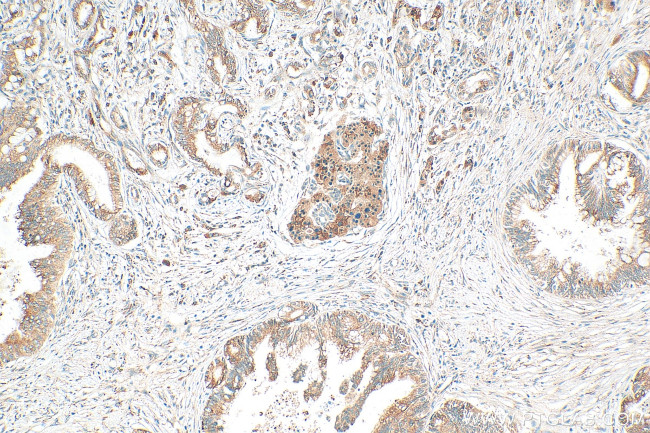
PLCD4 Antibody in Immunohistochemistry (Paraffin) (IHC (P))

Search
Proteintech
PLCD4 Polyclonal Antibody
{{$productOrderCtrl.translations['antibody.pdp.commerceCard.promotion.promotions']}}
{{$productOrderCtrl.translations['antibody.pdp.commerceCard.promotion.viewpromo']}}
{{$productOrderCtrl.translations['antibody.pdp.commerceCard.promotion.promocode']}}: {{promo.promoCode}} {{promo.promoTitle}} {{promo.promoDescription}}. {{$productOrderCtrl.translations['antibody.pdp.commerceCard.promotion.learnmore']}}
产品信息
30133-1-AP
种属反应
宿主/亚型
分类
类型
抗原
偶联物
形式
纯化类型
保存液
内含物
保存条件
运输条件
产品详细信息
Immunogen sequence: MASLLQDQLT TDQDLLLMQE GMPMRKVRSK SWKKLRYFRL QNDGMTVWHA RQARGSAKPS FSISDVETIR NGHDSELLRS LAEELPLEQG FTIVFHGRRS NLDLMANSVE EAQIWMRGLQ LLVDLVTSMD HQERLDQWLS DWFQRGDKNQ DGKMSFQEVQ RLLHLMNVEM DQEYAFSLFQ AADTSQSGTL EGEEFVQFYK ALTKRAEVQE LFESFSADGQ KLTLLEFLDF LQEEQKERDC TSELALELID RYEPSDSGKL RHVLSMDGFL SYLCSKDGDI FNPACLPIYQ
靶标信息
This gene encodes a member of the delta class of phospholipase C enzymes. Phospholipase C enzymes play a critical role in many cellular processes by hydrolyzing phosphatidylinositol 4,5-bisphosphate into two intracellular second messengers, inositol 1,4,5-trisphosphate and diacylglycerol. Expression of this gene may be a marker for cancer.
仅用于科研。不用于诊断过程。未经明确授权不得转售。
篇参考文献 (0)
生物信息学
蛋白别名: 1-phosphatidylinositol 4,5-bisphosphate phosphodiesterase delta-4; 1-phosphatidylinositol-4,5-bisphosphate phosphodiesterase delta-4; hPLCD4; phosphoinositide phospholipase C delta-4; Phosphoinositide phospholipase C-delta-4; Phospholipase C-delta-4; PLC delta4; PLC-delta-4; PLCd4b; unnamed protein product
基因别名: PLCD4
UniProt ID: (Human) Q9BRC7, (Rat) Q62711
Entrez Gene ID: (Human) 84812, (Rat) 140693